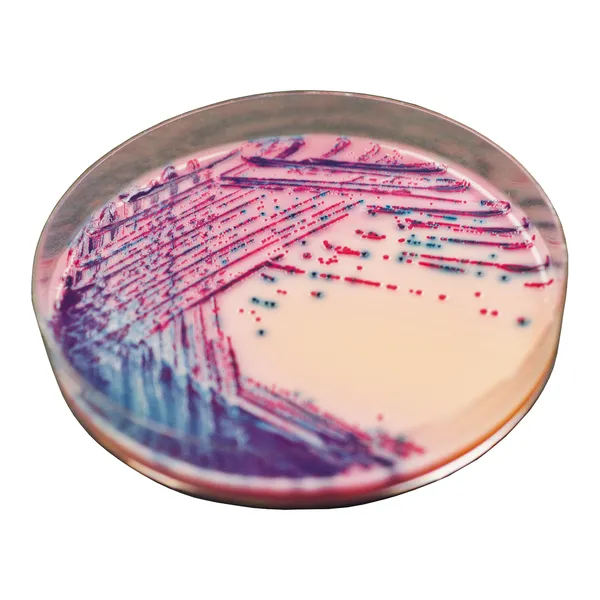
Rambach™ Agar

Hình thái khuẩn lạc

Salmonella
Đỏ

Coliformes
Xanh dương, tím
Hiệu năng
Hiệu năng
Mặc dù được phát hiện từ những năm 1880, Salmonella vẫn là một tác nhân gây bệnh quan trọng trên toàn thế giới và là một trong những nguyên nhân phổ biến nhất gây nhiễm trùng thực phẩm. Ví dụ, tại Mỹ, Salmonella có tỷ lệ mắc là 16,2 trường hợp trên 100.000 (ước tính của CDC, 2008).
Chủ yếu do ô nhiễm trong chuỗi thực phẩm và/hoặc trong các quá trình sản xuất thực phẩm, Salmonella thường gây bệnh đường tiêu hóa với các triệu chứng chính là đau quặn bụng, tiêu chảy, buồn nôn, nôn mửa. Những trường hợp nghiêm trọng hơn, chẳng hạn như bệnh thương hàn hoặc nhiễm trùng ở bệnh nhân suy giảm miễn dịch, có thể dẫn tới mất nước cơ thể với suy thận hoặc nhiễm khuẩn huyết.
Điều này nhấn mạnh tầm quan trọng của việc kiểm soát liên tục Salmonella dọc theo toàn bộ chuỗi sản xuất thực phẩm. Việc xét nghiệm quy mô lớn chỉ có thể thực hiện được với các công cụ phát hiện hiệu quả.
1. Đáng tin cậy: Môi trường chromogen thương mại đầu tiên (1989) dành cho Salmonella vẫn thành công cho đến ngày nay, nhờ vào hiệu năng của nó. Nó cũng có thể được sử dụng với mẫu lâm sàng.
4. Màu đỏ thẫm : giúp dễ đọc, so với các môi trường chromogen khác.
5. Kết quả nhanh : đặc biệt hữu ích trong trường hợp bùng phát nhanh, nguy hiểm của ngộ độc thực phẩm do Salmonella.
2. Độ đặc hiệu cao / ít tốn công :
Các môi trường truyền thống để phát hiện Salmonella qua đặc điểm H2S có độ đặc hiệu rất thấp, tạo ra rất nhiều kết quả dương tính giả (Citrobacter, Proteus, v.v.) trong số ít kết quả dương tính thực sự của Salmonella.
Khối lượng công việc để kiểm tra không cần thiết các khuẩn lạc nghi ngờ là rất lớn đến mức các khuẩn lạc Salmonella dương tính thực sự có thể bị bỏ sót trong xét nghiệm thường xuyên. Do độ đặc hiệu kém, các môi trường truyền thống đòi hỏi phải kiểm tra kỹ lưỡng ít nhất 10 khuẩn lạc cho mỗi mẫu nghi ngờ.
Ngược lại, Thạch Rambach™ loại bỏ hầu hết các trường hợp dương tính giả và cho phép kỹ thuật viên tập trung vào các mẫu thực sự bị nhiễm.
3. Độ nhạy rất cao : Salmonella → 93,9 %*
*Độ nhạy từ nghiên cứu khoa học: Gruenewald, R. et al. 1991. Sử dụng Thạch Chứa Propylene Glycol Rambach để Nhận diện Salmonella spp. J.C.M. 29: 2354-2356.
Thành phần

Tài liệu kỹ thuật
Công bố khoa học
1998
Rambach Agar as a new plate differential medium for the identification of some enteric pathogens in meat products
? Publication1994
Improved rapid method for isolation and enumeration of Salmonella from bivalves using Rambach Agar
? Publication1994
Evaluation of motility enrichment on modified semisolid Rappaport-Vassiliadis medium (MSRV) and automated conductance in combination with Rambach Agar for Salmonella detection in environmental samples of a milk powder factory
? Publication1992
Intérêt du milieu Rambach pour l’isolement et l’identification rapide des Salmonella. Laudat P. et al.
? Publication1991
Use of Rambach propylene glycol containing agar for identification of Salmonella spp.
? Publication1990
New plate medium for facilitated differentiation of Salmonella spp. from Proteus spp. and other enteric bacteria
? Publication

Xem thêm